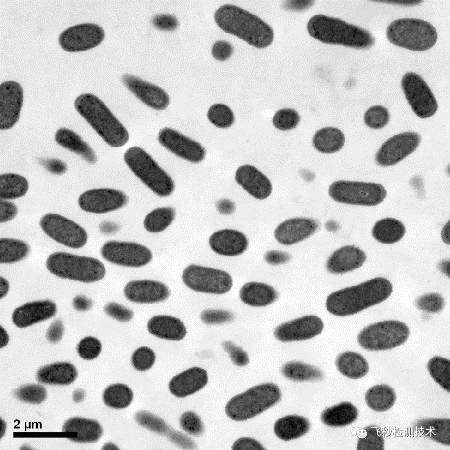

細菌究竟是怎樣被殺滅的?我們用透射電鏡來揭秘
發布時間: 2020-2-21 17:03:36 發布人: 飛秒檢測
現在全國新冠肺炎的態勢稍顯緩和,很多地方政府也開始積極引導企業復工,同時也強調復工的同時要用消殺產品清除病毒防止傳染。所以當下幾乎每個人都對消毒滅菌有了基本的認識和,但是對細菌和病毒的殺滅究竟是怎樣一個過程?是否有顯而易見的方式讓大家理解滅菌的過程?為此,飛秒檢測電鏡部門的工程師花了一些時間給大家圖文并茂的展示,細菌是如何被殺滅,話不多說,請看下文
研究手段展示

研究工具:JEM-2100透射電鏡
該透射電鏡的主要指標參數如下:
-
點分辨率:0.23 nm
-
線分辨率:0.14 nm
-
加速電壓:80, 100, 120, 160, 200kV
-
束斑尺寸:1.0至25 nm
-
放大倍數(高倍模式):2000至1,500,000
-
放大倍數(低倍模式):50至6,000
-
CCD分辨率:4008×2672 max
大腸桿菌的繁殖過程
在揭示大腸桿菌被殺滅的過程,先了解一下大腸桿菌恐怖的繁殖速度。一般情況下大腸桿菌20分鐘就分裂一次,單個細菌在24小時后可產生4722×10的21次方個后代,總重可達4722×10的3次方千克,若將細菌平鋪在地球表面,它這一大家子就可以把地球完全覆蓋,多么驚人的繁殖力!
大腸桿菌的死亡過程

肉眼下的大腸桿菌
放大1萬倍的大腸桿菌

放大1萬5千倍的大腸桿菌

放大6萬倍的正常的大腸桿菌

放大6萬倍被滅菌劑噴灑過的大腸桿菌(0.1h)
從圖中可以看出細胞壁已經被破壞

放大6萬倍被滅菌劑噴灑過的大腸桿菌(0.3h)
上圖中可以看出細菌的內容物已經流出而死亡
從上文可以看出,消殺產品對細菌的殺滅是立竿見影的。消殺產品可以直接破壞細菌的細胞壁,從而導致細胞的破碎,內容物流出,從而徹底死亡。
歡迎大家關注飛秒檢測技術微信公眾號,我們將在下周給大家展示金黃色葡萄球菌的死亡過程,感謝大家的關心和關注!
